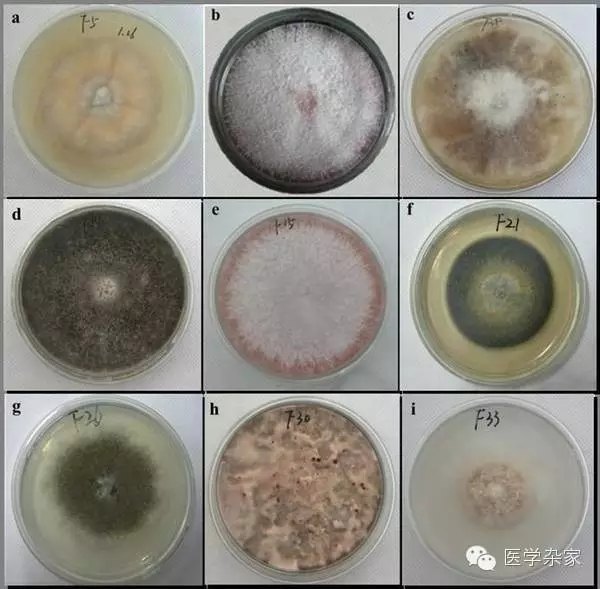
为什么脚气莫名其妙没有了,为什么脚气总是不能断根

脚气是常见病!
门诊患者经常问的一句话是:“为什么我的脚气总是断不了根?搽几天药膏就好了, 可过不了几天,就又犯了。”为此,总免不了一番解释。
到底是什么原因导致脚气总是断不了根呢?在此做一简述,希望对大家有所帮助,能够明白问题所在。
断不了根的原因有两大类:复发和再发。
复发,是脚上的真菌并没有完全清除,在不规律的外用抗真菌药膏后,真菌暂时受到了抑制,表现得不那么活跃,临床症状有所减轻,就停止了用药,几天后,没被杀死的真菌,死灰复燃,再次大量繁殖,脚气就又发生了。
再发,是脚上的真菌已经被完全清除,但因为不注意个人卫生,又再次感染了真菌,比如下雨天踩脏水,共用拖鞋,等,真菌再次感染足部,引发的脚气。
市场上常见的治疗脚气的药有多种:什么水呀膏的,都有,但疗效不一,即使有效,也是暂时的缓解,不能从根本上解决问题。那到底是什么原因导致脚气不能彻底治愈呢?

原因一:引起脚气的真菌有多种,比如皮肤癣菌、犬小孢子菌、红色毛癣菌、白色念珠菌等等,这些真菌并不是对所有的抗真菌药都敏感,同时,每一种抗真菌药也不是对所有的真菌都有效。同是脚气,感染的真菌不一样,那么治疗效果也不一样。别人用了有效的药膏,你用了可能就没效。此外,发生脚气时,感染的真菌可能不至一种,一般是混合性感染,这就给彻底治愈带来了难度。
原因二:即使所用的药膏有效,在使用时也很难做到全方位覆盖。因为你所搽药膏之处均为严重的有症状的部位,但真菌的感染并仅仅限局于这些部位。比如你的第4、5脚趾缝糜烂,你可能误以为只有这个脚趾缝间有真菌感染,便把药膏搽在这个位置,其他地方没有病变,也就不会搽药膏。其实,真菌的分布要比临床表现中病变部位范围要大得多,只搽病变部位,可以缓解严重症状,但并不能彻底将真菌从脚上清除。因此,也就为停药后复发埋下了隐患。

原因三:真菌有休眠期。真菌在条件适宜时出芽繁殖生长,这时候最容易被抗真菌药物杀死。但真菌在外部条件不佳时,选择不生长,变成孢子,因为孢子的壁比较厚,药物难于渗透进去,因此也就难以将真菌斩草除根。等外部条件成熟时,孢子又会开始出芽繁殖,新的一轮感染又来了。

原因四:再次感染真菌。夏季是足癣的高发季节,为什么呢?夏天雨水多,人们经常穿凉鞋,踩到脏水的机会也就大大增加了。因为环境中到处遍布着真菌,赶上梅雨季节,筷子都会长毛,墙上都会长苔。因此,很多病人都是在雨天踩水后一周左右去医院看病,毫无疑问是得了足癣。另外,同学之间、同事之间、家人之间共用拖鞋,也是诱发脚气的一大原因。很多人都有这样的类似经历:我本来没脚气,穿了谁的拖鞋之后就被染上脚气了。是这样的,因此,要避免和他人共用拖鞋,避免交叉感染。

原因五:灰指甲是最顽固的一个碉堡。患多年脚气的病友常合并有灰指甲,它就象一个坚固的碉堡,周围都扫荡平了,这里却还是固若金汤。因为,真菌感染深至甲床,药物触及不到,同时甲板厚,药物不易透过。就象旁边放了个定时*弹炸**,虽时都有再复发的可能。因此,彻底治愈灰指甲也是预防足癣复发的一项重要举措。

综上所述,脚气的复发或再发,是多因素造成的。了解了这些原因,那么再预防脚气复发或再发,就有了方向。脚气属于感染性疾病,是能够治愈的,所以大家即使得了脚气或者是灰指甲,也不要烦恼,只要找对方法,治愈是没问题的。
最后,祝大家都有一双完美无瑕的玉足!
@头条健康联盟 @头条健康 @大众家庭医生 @麻醉超人钢铁侠 @京虎子 @皮肤科徐宏俊医生 @皮肤科医生胡云峰 @*今条头日** @丁香医生 @健康真相官